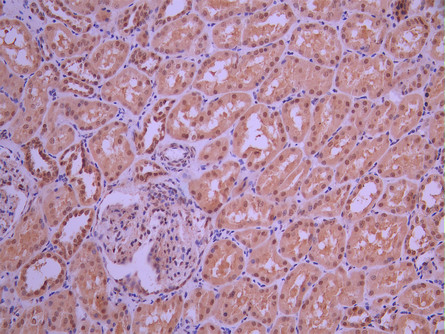

RNF7 Recombinant Monoclonal Antibody
-
中文名稱:RNF7 Recombinant Monoclonal Antibody
-
貨號:CSB-RA776042A0HU
-
規(guī)格:¥1320
-
圖片:
-
Western Blot
Positive WB detected in: Hela whole cell lysate(30μg), HepG2 whole cell lysate(30μg), COLO-205 whole cell lysate(30μg), A431 whole cell lysate(30μg)
All lanes: RNF7 antibody at 1:1000
Secondary
Goat polyclonal to rabbit IgG at 1/40000 dilution
Predicted band size: 13 kDa
Observed band size: 13 kDa
Exposure time:2min -
IHC image of CSB-RA776042A0HU diluted at 1:100 and staining in paraffin-embedded human kidney tissue performed on a Leica BondTM system. After dewaxing and hydration, antigen retrieval was mediated by high pressure in a citrate buffer (pH 6.0). Section was blocked with 10% normal goat serum 30min at RT. Then primary antibody (1% BSA) was incubated at 4°C overnight. The primary is detected by a Goat anti-rabbit polymer IgG labeled by HRP and visualized using 0.05% DAB.
-
IHC image of CSB-RA776042A0HU diluted at 1:100 and staining in paraffin-embedded human liver cancer performed on a Leica BondTM system. After dewaxing and hydration, antigen retrieval was mediated by high pressure in a citrate buffer (pH 6.0). Section was blocked with 10% normal goat serum 30min at RT. Then primary antibody (1% BSA) was incubated at 4°C overnight. The primary is detected by a Goat anti-rabbit polymer IgG labeled by HRP and visualized using 0.05% DAB.
-
Overlay Peak curve showing 786-O cells stained with CSB-RA776042A0HU (red line) at 1:100. The cells were fixed in 4% formaldehyde and permeated by 0.2% TritonX-100 for 10min. Then 10% normal goat serum to block non-specific protein-protein interactions followed by the antibody (1ug/1*106cells) for 45min at 4℃. The secondary antibody used was FITC-conjugated goat anti-rabbit IgG (H+L) at 1/200 dilution for 35min at 4℃.Control antibody (green line) was Rabbit IgG (1ug/1*106cells) used under the same conditions. Acquisition of >10, 000 events was performed.
-
-
其他:
產品詳情
-
Uniprot No.:
-
基因名:
-
別名:CKBBP 1 antibody; CKBBP1 antibody; CKII beta binding protein 1 antibody; CKII beta-binding protein 1 antibody; Rbx 2 antibody; Rbx2 antibody; RBX2_HUMAN antibody; Regulator of cullins 2 antibody; RING box protein 2 antibody; RING finger protein 7 antibody; RING-box protein 2 antibody; RNF 7 antibody; RNF7 antibody; ROC 2 antibody; ROC2 antibody; SAG antibody; Sensitive to apoptosis gene antibody; Sensitive to apoptosis gene protein antibody; Zinc RING finger protein SAG antibody
-
反應種屬:Human
-
免疫原:A synthesized peptide from human RNF7 protein
-
免疫原種屬:Homo sapiens (Human)
-
標記方式:Non-conjugated
-
克隆類型:Monoclonal
-
抗體亞型:Rabbit IgG
-
純化方式:Affinity-chromatography
-
克隆號:8C10
-
濃度:It differs from different batches. Please contact us to confirm it.
-
保存緩沖液:Rabbit IgG in 10mM phosphate buffered saline , pH 7.4, 150mM sodium chloride, 0.05% BSA, 0.02% sodium azide and 50% glycerol.
-
產品提供形式:Liquid
-
應用范圍:ELISA, WB, IHC, FC
-
推薦稀釋比:
Application Recommended Dilution WB 1:500-1:5000 IHC 1:50-1:200 FC 1:50-1:200 -
Protocols:
-
儲存條件:Upon receipt, store at -20°C or -80°C. Avoid repeated freeze.
-
貨期:Basically, we can dispatch the products out in 1-3 working days after receiving your orders. Delivery time maybe differs from different purchasing way or location, please kindly consult your local distributors for specific delivery time.
-
用途:For Research Use Only. Not for use in diagnostic or therapeutic procedures.
相關產品
靶點詳情
-
功能:Probable component of the SCF (SKP1-CUL1-F-box protein) E3 ubiquitin ligase complex which mediates the ubiquitination and subsequent proteasomal degradation of target proteins involved in cell cycle progression, signal transduction and transcription. CRLs complexes and ARIH1 collaborate in tandem to mediate ubiquitination of target proteins, ARIH1 mediating addition of the first ubiquitin on CRLs targets. Through the RING-type zinc finger, seems to recruit the E2 ubiquitination enzyme to the complex and brings it into close proximity to the substrate. Promotes the neddylation of CUL5 via its interaction with UBE2F. May play a role in protecting cells from apoptosis induced by redox agents.
-
基因功能參考文獻:
- We demonstrated that RNF7 knockdown induced growth suppression of prostate cancer cells and inactivated ERK1/2 pathway, which suggested RNF7 might be a potential novel therapeutic target for CRPC. PMID: 28252001
- Results identified RNF7 to interact with CARMA2 regulating its NF-kappaB-activating capacity. Mechanistically, RNF7 influences CARMA2 signaling by regulating the ubiquitination state of MALT1 and the NF-kappaB-regulatory molecule NEMO. PMID: 29194363
- Sag is a Kras-cooperating oncogene that promotes lung tumorigenesis PMID: 24430184
- NEDD4-1 overexpression sensitizes cancer cells to etoposide-induced apoptosis by reducing SAG levels through targeted degradation. SAG is added to a growing list of NEDD4-1 substrates and mediates its biological function. PMID: 25216516
- RNF7 gene variant is associated with the risk of developing liver fibrosis and cirrhosis in an Eastern European population. PMID: 28338112
- MAF1, RNF7 and SETD3 are identified as PCNA-associated proteins in human cells and given this interaction with PCNA, Maf1, RNF7, and SetD3 are potentially involved in DNA replication, DNA repair, or associated processes. PMID: 26030842
- These findings indicate that Rbx1 and Rbx2 can both activate Cul5-Vif E3 ligase in vitro, but they may undergo a more delicate selection mechanism in vivo. PMID: 25912140
- Single nucleotide polymorphism rs16851720 was associated with liver fibrosis progression. PMID: 22841784
- Data suggest that the sensitive-to-apoptosis gene may be a candidate gene for good prognosis in rectal cancer, independent of therapeutic response of different individuals. PMID: 22171132
- SAG plays an important role in regulating ionizing radiation-induced apoptosis PMID: 20933570
- The findings showed that SAG E3 ubiquitin ligase plays an essential role in cancer cell proliferation and tumor growth PMID: 20103673
- SAG possesses a potent peroxidase property to decompose hydrogen peroxide in the presence of dithiothreitol PMID: 11999705
- results show that the Ring-H2 finger motif of CKBBP1 is necessary for efficient binding to CKIIbeta, as well as for optimal cell proliferation PMID: 12470599
- sensitive to apoptosis gene protein inhibits peroxynitrite-induced DNA damage. PMID: 12565832
- results indicate that protein kinase CKII may control IkappaBalpha and p27Kip1 degradation and thereby G1/S phase transition through the phosphorylation of threonine 10 within CKBBP1 protein PMID: 12748192
- These studies suggested that CK2 might regulate SAG-SCF E3 ligase activity through modulating SAG's stability, rather than its enzymatic activity directly. PMID: 16874460
- Endogenous levels of pro-caspase 3 were decreased by overexpression of SAG protein. PMID: 17217622
- Promotes hypoxia-inducible factor 1 alpha subunit (HIF-1 alpha) ubiquitination and degradation. PMID: 17828303
- Sensitive to apoptosis gene may play an important role in regulating the apoptosis induced by heat shock presumably through maintaining the cellular redox status. PMID: 18454945
顯示更多
收起更多
-
亞細胞定位:Cytoplasm. Nucleus.
-
蛋白家族:RING-box family
-
組織特異性:Expressed in heart, liver, skeletal muscle and pancreas. At very low levels expressed in brain, placenta and lung.
-
數(shù)據(jù)庫鏈接:
Most popular with customers
-
-
YWHAB Recombinant Monoclonal Antibody
Applications: ELISA, WB, IHC, IF, FC
Species Reactivity: Human, Mouse, Rat
-
Phospho-YAP1 (S127) Recombinant Monoclonal Antibody
Applications: ELISA, WB, IHC
Species Reactivity: Human
-
-
-
-
-